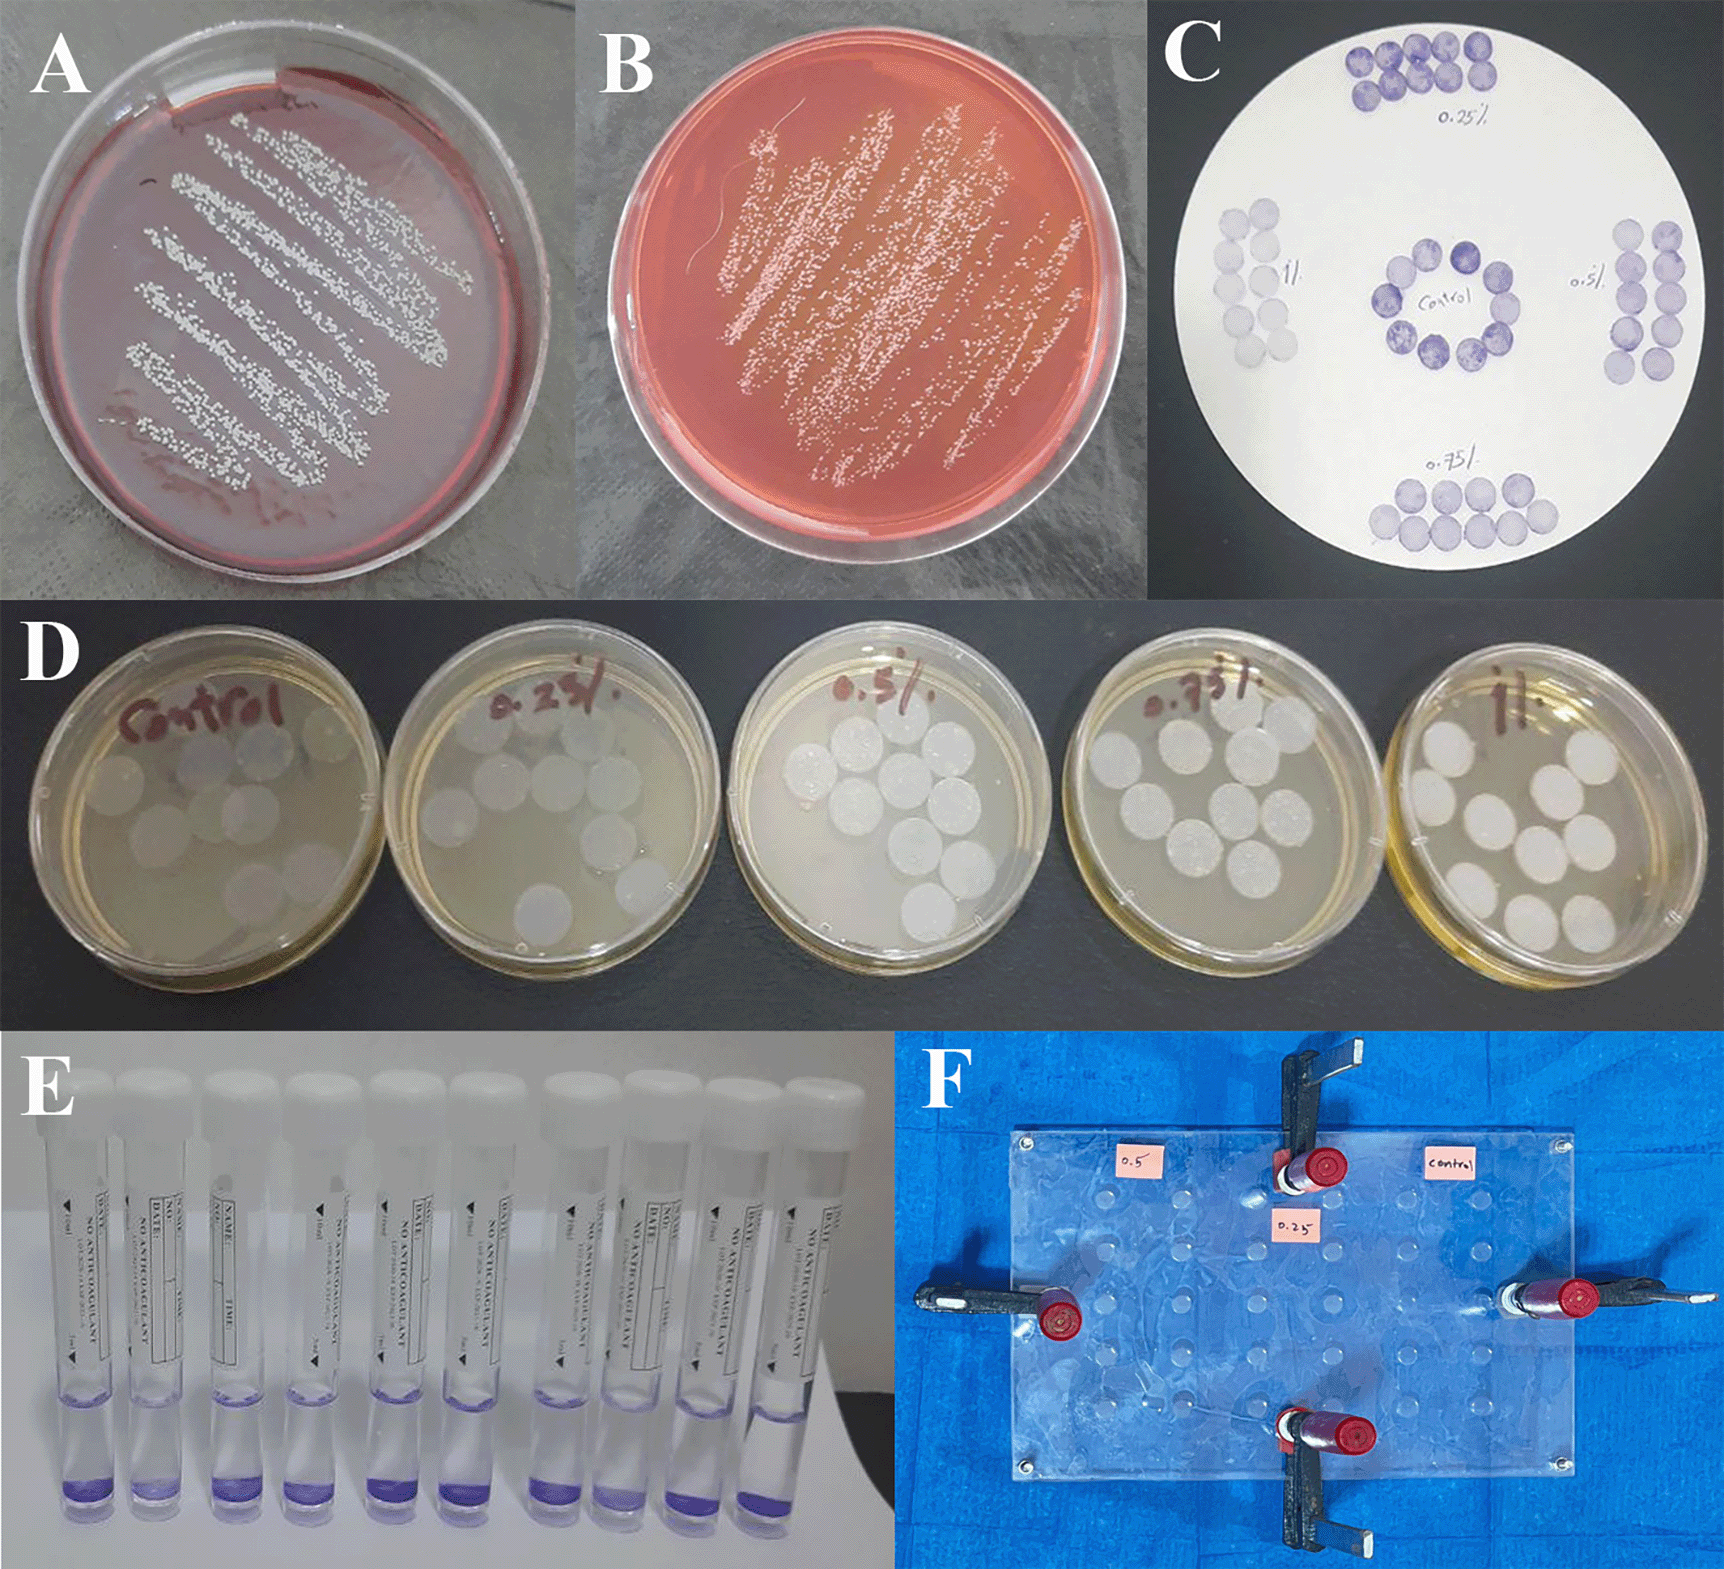

Keywords
barium titanate (BaTiO3), VST-50 silicone elastomer, bacterial adhesion, Staphylococcus epidermidis.
barium titanate (BaTiO3), VST-50 silicone elastomer, bacterial adhesion, Staphylococcus epidermidis.
The restoration of abnormalities resulting from inherited or acquired causes, such as cancer or trauma, has often utilized prosthetic devices. Due to the location and extent of the lesion, surgery may not always be a solution; hence, the need for prosthetic rehabilitation has grown correspondingly.1
Any abnormality that develops in the body, especially in the head and neck area, has a negative impact on the patient’s attractiveness, function, social acceptability, and psychological confidence. The most vital and difficult part of these individuals’ therapy is rehabilitation. Any rehabilitation process attempts to reintroduce the patient into society in a condition that is close to normal. A facial prosthesis preserves the tissues of a defect, restores normal anatomy and appearance, and offers the patient significant psychological benefits.2
Maxillofacial prosthetics can be made from a variety of materials, such as chlorinated polyethylene, polyvinyl chloride, polyurethanes, polymethyl methacrylate, and polydimethylsiloxane.
Silicone elastomers have become more important in medicine and the construction of maxillofacial prostheses because of their strength, durability, ease of manipulation, esthetics, and flexibility.1,3 Currently, no facial prosthetic material, including silicone, satisfies all the requirements for a satisfactory prosthesis. The primary cause of routine facial prosthetic replacement is deterioration in appearance caused by changes in physical characteristics and color.3 Therefore, silicone maxillofacial material requires reinforcement.
During the development of the nanoparticle industry, nanoparticles have been incorporated into the polymer matrix as fillers to provide a modified polymer characterized by improved features gained from the reinforcing action of the nanoparticles. The expected mechanical, physical, and biological properties of a silicone elastomer depend on the type and amount of filler added to the polymer. These little additions could enhance certain characteristics of the material.1
Biofilm formation on the surface of maxillofacial prostheses is one of the most critical problems. Biofilms are formed due to various reasons, such as fungal, bacterial, and commensal microflora. These microbes have a clear association with reports of bacterial dermatitis and endophthalmitis.5 Among the different species found, the most frequent have been Staphylococcus aureus and Staphylococcus epidermidis. The major limitation of maxillofacial silicone is that it has numerous porosities on its surface that are colonized by these microorganisms.4,5
Staphylococcus epidermidis is the most prevalent commensal bacteria on human skin. Although S. epidermidis defends us against foreign invasion, it also takes advantage of human weakness when it has the chance. Such chances appear in immunocompromised people or when biomedical implants provide a chance for surface colonization and biofilm formation.6
The physical rubbing or brushing of maxillofacial prostheses is one method of disinfection, although it is not perfectly advised since the repetitive cleaning might roughen the material’s surface. Similar chemical immersion, for example, repeated use of chlorhexidine gluconate CHX, may change the physical and mechanical characteristics of maxillofacial silicone elastomers, resulting in roughness, color change, and an increase in microhardness.5
Incorporation of a nanoparticle such as Barium Titanate (BaTiO3) may enhance the antimicrobial and other properties of maxillofacial silicon. Barium titanate (BaTiO3), a dielectric/ferroelectric semiconductor, is the most extensively used photocatalyst in environmental and medical applications due to its low cost, chemical stability, biocompatibility, and non-toxicity. BaTiO3 has been proven to accelerate osteogenesis, and the same material in nanoparticle form acts as a second harmonic generation (SHG) probe to identify Osteogenesis Imperfecta.7,8
BaTiO3 had shown antibacterial activity against numerous types of bacteria when added to different materials such as polyvinylsiloxane, hydroxyapatite, and implants.9,23 This study aimed to evaluate the effect of BaTiO3 on S. epidermidis biofilm adhesion after addition to VST-50 maxillofacial silicone in various weight percentages.
Barium Titanate (BaTiO3) (Sky Spring Nanomaterials, USA) and VST-50 room temperature vulcanized silicone (Factor II Inc., USA) were used.
Particle size analyzer was used to verify that the BaTiO3 particles are at the nanoscale, and the effective diameter was (59.4 nm).
50 specimens were prepared and categorized equally into five groups: one control group (0wt% BaTiO3) and four experimental groups (0.25wt%, 0.5wt%, 0.75wt%, and 1wt% BaTiO3) 10 specimens for each group.
Three clear acrylic sheets (the matrix, bottom, and cover) with 2 ± 0.05 mm thickness were created. The matrix sheet was designed with 10 mm disk-shaped perforations and was glued to the bottom sheet by chloroform (glue material) to avoid its moving while silicone was being poured. Using a computer’s software (CorelDraw 2020) to design the mold and a CNC machine to fabricate it. Clamps, screws, and nuts were also used for further tightening at the edges,1,10 an alternative open-source software is FreeCAD.
In accordance with the manufacturer’s instructions, the VST-50 maxillofacial silicone is mixed at a ratio of 10:1 (10 parts base to 1 part catalyst). A vacuum mixer had been used to prevent air entrapment.
Specimens for the control group were mixed by using an electronic digital balance (to 3 dp) for weighing the base and catalyst, then mixed for 5 minutes.
For the experimental groups, BaTiO3 filler was first weighted and added to the bowl, followed by the addition of the base part to the filler. The mixture was mixed for 3 minutes without vacuum to avoid suction of the filler, followed by 7 minutes of mixing with air suction. The vacuum pressure is set to -10 bar (-28 inch Hg), and the speed is set to 140 ± 10 rpm. The mixture was then allowed to cool for 5 minutes. The catalyst was then added to the base-filler mixture and mixed for 5 minutes.11,12
The mixture was poured into the mold, and the cover part was sealed over it. The mold was tightened by screws, nuts, and G-clamps. The mixture was left to set at (23°С ± 2°С) for 24 hours according to the manufacturer’s instructions. The specimens were stored at 20-25°C, 50 ± 10% humidity, and for 16 hours according to ISO 23529:2016 (Figure 1F).13
S. epidermidis was isolated from three patients using sterile transport cotton swabs. By rotating the transport swab across the contaminated skin region, necrotic tissue was avoided.14 It was then inoculated into blood agar and mannitol salt agar prepared according to the manufacturer’s instructions in an aerobic condition at 37 °C for 48 hours (Figure 1A and B).15 Identification of S. epidermidis: they form grayish-white, elevated, round, smooth, cohesive, 1–2 mm in diameter non-hemolytic colonies. They showed positive results in the catalyst test, and bacterial species were verified using the VITEK 2 compact identification system.
Bacterial adherence test
This test was performed to evaluate the antibacterial activity of BaTiO3 against S. epidermidis, depending on optical density (OD) measurement using a spectrophotometer (APEL PD-303, Japan) set at 600 nm.16 Brain heart infusion broth was used to grow and create the bacterial suspension. It was prepared according to the manufacturer’s instructions by suspending 34.5 grams of powder in one liter of distilled water and dissolving it completely, then autoclaved at 15 lbs. of pressure (121°C) for 15 minutes. Then a suspension of 107 colony forming units (CFU/ml) (0.5 McFarland standards) was prepared using a McFarland densitometer. The silicone specimens were sterilized for 20 minutes in an autoclave at 121°C. The sterile silicone specimens were placed in a sterile plastic dish containing the produced bacterial solution and incubated at room temperature for one hour (Figure 1D).10 Following completion of the incubation time, the specimens were withdrawn from the suspension, rinsed twice with phosphate-buffered saline for one minute with gentle rocking to remove any non-adherent bacterial cells, and dried on filter paper.10 The specimens were then stained by 1% crystal violet for 10 minutes and rinsed well in phosphate-buffered saline (Figure 1C).17 Each specimen was immersed in 3 ml of 96% ethanol alcohol for 3 minutes; this solution was then used to confirm the optical density of each specimen (Figure 1E).18
Fourier transforms infrared spectroscopy (FTIR)
FTIR (IRAffinity-1 laser product, Shimadzu, Japan) was utilized to verify if silicone material and the BaTiO3 nanoparticles interacted chemically. Three samples, one from each group, were examined. (Control, 0.5wt% and 0.75wt%).
Field emission scanning electron microscope (FE-SEM)
The scattering of BaTiO3 nanoparticles within the silicone specimen matrix was evaluated using a FE-SEM (FEI, Netherland) machine. Three samples were tested, one from each group (control, 0.5wt% and 0.75wt%).
The statistical analysis was performed using one-way ANOVA (analysis of variance) and post hoc tests (Games-Howell) by statistical analysis software (IBM SPSS Statistics 23, a proprietary free alternative we can suggest is PSPP). The Shapiro-Wilk test was used to discover the normality distribution of data, and Levene’s test was used to discover if the variances were homogenous.
The probability (P) value was considered non-significant statistically (NS) when (P > 0.05), while P value was considered statistically significant (S) when (P ≤ 0.05), and P value was considered highly significant (HS) when (P ≤ 0.01).
FTIR Results: There was no change in the spectra range of VST-50 silicone by the incorporation of BaTiO3 (no chemical interaction) as shown in Figure 2.

FE-SEM result: the BaTiO3 nanoparticles were evenly distributed throughout the VST-50 silicone matrix in the FE-SEM images, with slight agglomeration as filler loading increased, as shown in Figure 3. FE-SEM showed reduced silicone porosity.

The Shapiro-Wilk test revealed a normal distribution of data around the mean (P value ˃ 0.05) (Table 1).
| Shapiro-Wilk test | |||
|---|---|---|---|
| Group | Statistic | df | Sig. |
| Control | 0.974 | 10 | 0.923 |
| 0.25wt% | 0.921 | 10 | 0.368 |
| 0.5wt% | 0.937 | 10 | 0.520 |
| 0.75wt% | 0.940 | 10 | 0.550 |
| 1wt% | 0.848 | 10 | 0.055 |
The descriptive statistic revealed a decrease in the mean of optical density (OD) as the concentration of BaTiO3 increased, which represented a decrease in bacterial adhesion (Table 2), as shown in Figure 4.

One-way ANOVA test revealed a highly significant difference in the mean values among all groups (P < 0.01) (Table 3).
| Sum of Squares | df | Mean Square | F | P value | |
|---|---|---|---|---|---|
| Between groups | 0.007 | 4 | 0.002 | 144.515 | 0.000 HS |
| Within groups | 0.001 | 45 | 0.000 | ||
| Total | 0.008 | 49 |
To choose the type of multiple comparison post hoc test and assess the homogeneity of variances, Levene’s test was used (Table 4).
| Levene Statistic | df1 | df2 | P value | Sig. |
|---|---|---|---|---|
| 7.762 | 4 | 45 | 0.000 | S |
Games-Howell test, revealed a highly significant difference between groups (P < 0.01). except there was a significant difference between 0.75wt% group and 1wt% group at (P < 0.05) (Table 5).
Long-term usage of maxillofacial prostheses encourages the colonization of microorganisms on the silicone surface and spreads infection to nearby tissues; similarly, biofilm may transfer from infected skin to the prosthesis.4
As previously stated, prolonged physical and chemical immersion disinfectants may result in material deterioration and color change, and the removal of bacterial accumulation is essential for external prostheses.
Additionally, it’s essential to discover a cleaning technique that is both effective in preventing infections and silicone prosthesis degeneration.19 Due to the potential for a toxic or adverse effect, the use of any antimicrobial must be limited. The development of bacterial antibiotic resistance is one of the most urgent problems facing worldwide health care. In recent years, due to fewer side effects and effective antimicrobial activity, the use of oxides instead of chemical or synthetic medicine has increased.20–22
In this investigation, it was shown to have an antibacterial action against the aforementioned bacteria since, as shown in Table 2, the percentages of bacterial cells adhering to the silicone specimens were dramatically reduced when compared to the control group.
Result of this study agreed with,9 as they found a long-term antibacterial effect of BaTiO3 against S. epidermidis at 24 hours when added to Polyvinylsiloxane (PVS) between 5% and 15%. They also stated that the antibacterial activity was due to the release of Ba2+ and the formation of TiO2, resulting in slightly acidic environments. Then, when Ba2+ and TiO2 interact with water, they both help to create hydroxyl radicals (OH) and free radicals (O2-) that destroy nucleic acids, bacterial cell walls, and other molecular structures.
Swain et al. found that the positively charged hydroxyapatite-BaTiO3 composite revealed antibacterial activity against S. aureus, E. coli, and P. aeruginosa with a remarkable inhibition zone. Positively polarized HA-BT composites rupture the bacterial membrane in vitro.23 Additionally, many studies have shown that barium titanate has antifungal activity.24,25
FTIR measurements were performed both prior to and following the addition of BaTiO3 nanoparticles. As the spectral range remained unchanged both prior to and following the addition, there was no chemical reaction. The only interaction in this case is described as a physical reaction (hydrogen bond or Van der Waals bond), and it results from fillers interacting with silicone. This interaction manifested as a slight change in the vibration of preexisting bonds and a change in the silicone matrix’s light transmittance. This confirms that the antibacterial activity is related to BaTiO3, as no new chemical material was produced, and explains the difference in antibacterial activity between the control and experimental groups.
FE-SEM revealed well dispersion of BaTiO3 inside the silicone matrix with some agglomeration as the filler percentage increased, and this agreed with.1,26 And disagreed with other studies because they utilized different fillers in varying quantities and agglomeration was only noticeable at higher percentages. This could be because surface-treated silicon dioxide nanoparticles were used; surface treatment impacts the dispersion of the nanofiller inside the matrix by decreasing the probability of nanoparticle aggregation.27,28
Another factor that affected the reduction in bacterial adhesion was reduced porosity. Many studies confirm that the addition of non-filler materials to various materials reduces porosity since the filler fills the space inside the matrix of materials.29,30 FE-SEM results showed reduced porosity of the silicone matrix, which reduces the opportunity for bacterial adhesion.
With respect to the limitations of this study, it can be concluded that the addition of BaTiO3 powder to VST-50 maxillofacial silicon elastomer will enhance the antibacterial activity of silicon against Staphylococcus epidermidis, and this activity seems to be concentration dependent. For further study we could evaluate the effect of the addition of BaTiO3 nanoparticles on the fungal biofilm’s adhesion to the maxillofacial silicones and study the effects of adding BaTiO3 nanoparticles to pigmented VST-50 RTV silicone elastomers. Evaluating the artificial aging of VST-50 RTV maxillofacial silicone after the addition of BaTiO3 nanopowder is another suggestion that could be explored.
Figshare. Antibacterial effect of Barium Titanate, https://doi.org/10.6084/m9.figshare.22336786.v1. 31
This project contains the following underlying data:
• Raw data. (optical density of bacterial test)
• FTIR data. (for BaTiO3 and for silicone before and after addition of BaTiO3)
• FE-SEM data (pictures for BaTiO3 and for silicone before and after addition of BaTiO3)
• VITEK 2 Microbiology Chart Report
• Pictures of steps of bacterial test
• Particle size analyzer report of barium titanate
Data are available under the terms of the Creative Commons Attribution 4.0 International license (CC-BY 4.0).
| Views | Downloads | |
|---|---|---|
| F1000Research | - | - |
|
PubMed Central
Data from PMC are received and updated monthly.
|
- | - |
Is the work clearly and accurately presented and does it cite the current literature?
Yes
Is the study design appropriate and is the work technically sound?
Partly
Are sufficient details of methods and analysis provided to allow replication by others?
Partly
If applicable, is the statistical analysis and its interpretation appropriate?
Yes
Are all the source data underlying the results available to ensure full reproducibility?
Yes
Are the conclusions drawn adequately supported by the results?
Yes
References
1. Chong WX, Lai YX, Choudhury M, Amalraj FD: Efficacy of incorporating silver nanoparticles into maxillofacial silicone against Staphylococcus aureus, Candida albicans, and polymicrobial biofilms.J Prosthet Dent. 2022; 128 (5): 1114-1120 PubMed Abstract | Publisher Full TextCompeting Interests: No competing interests were disclosed.
Reviewer Expertise: Microbiology
Is the work clearly and accurately presented and does it cite the current literature?
Yes
Is the study design appropriate and is the work technically sound?
Yes
Are sufficient details of methods and analysis provided to allow replication by others?
Yes
If applicable, is the statistical analysis and its interpretation appropriate?
Yes
Are all the source data underlying the results available to ensure full reproducibility?
Yes
Are the conclusions drawn adequately supported by the results?
Yes
Competing Interests: No competing interests were disclosed.
Reviewer Expertise: Material science and Nanotechnology, Laser application in medicine specially in dentistry
Is the work clearly and accurately presented and does it cite the current literature?
Yes
Is the study design appropriate and is the work technically sound?
Yes
Are sufficient details of methods and analysis provided to allow replication by others?
Yes
If applicable, is the statistical analysis and its interpretation appropriate?
I cannot comment. A qualified statistician is required.
Are all the source data underlying the results available to ensure full reproducibility?
Yes
Are the conclusions drawn adequately supported by the results?
Yes
Competing Interests: No competing interests were disclosed.
Reviewer Expertise: Dental biomaterials, application of nps
Alongside their report, reviewers assign a status to the article:
| Invited Reviewers | |||
|---|---|---|---|
| 1 | 2 | 3 | |
|
Version 2 (revision) 06 Nov 23 |
read | ||
|
Version 1 12 Apr 23 |
read | read | read |
Provide sufficient details of any financial or non-financial competing interests to enable users to assess whether your comments might lead a reasonable person to question your impartiality. Consider the following examples, but note that this is not an exhaustive list:
Sign up for content alerts and receive a weekly or monthly email with all newly published articles
Already registered? Sign in
The email address should be the one you originally registered with F1000.
You registered with F1000 via Google, so we cannot reset your password.
To sign in, please click here.
If you still need help with your Google account password, please click here.
You registered with F1000 via Facebook, so we cannot reset your password.
To sign in, please click here.
If you still need help with your Facebook account password, please click here.
If your email address is registered with us, we will email you instructions to reset your password.
If you think you should have received this email but it has not arrived, please check your spam filters and/or contact for further assistance.
Comments on this article Comments (0)